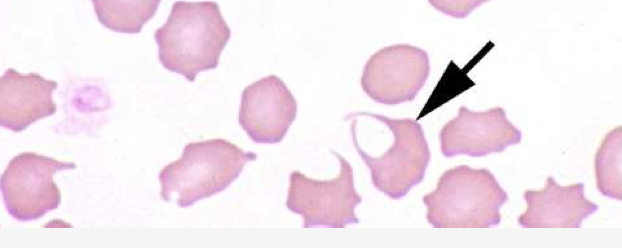
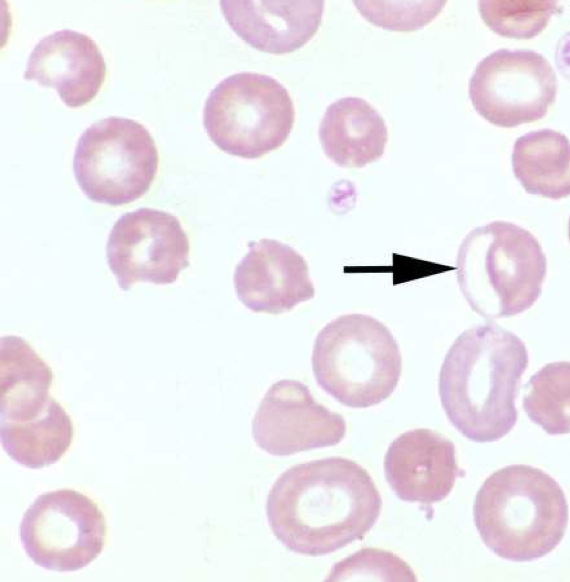
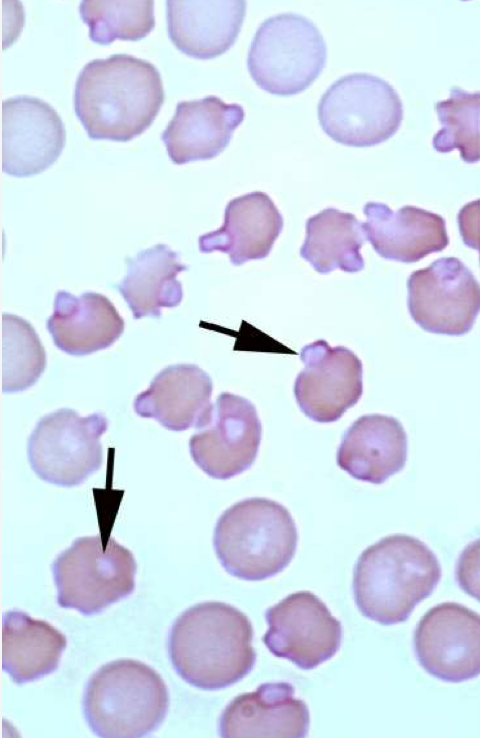
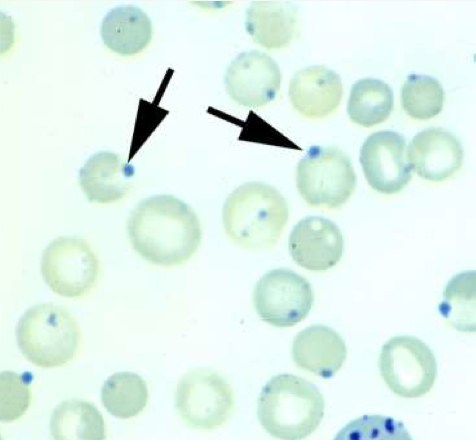
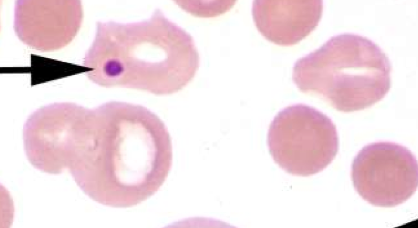
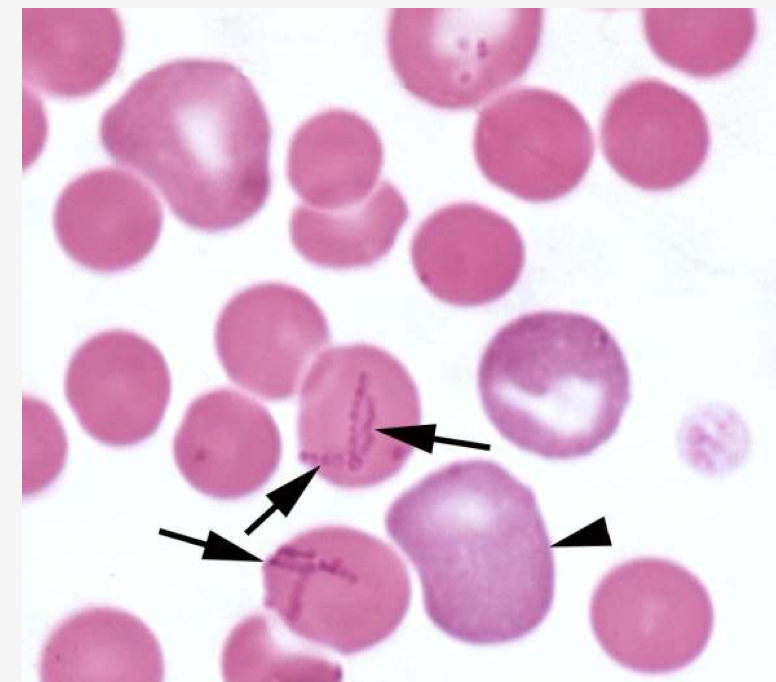
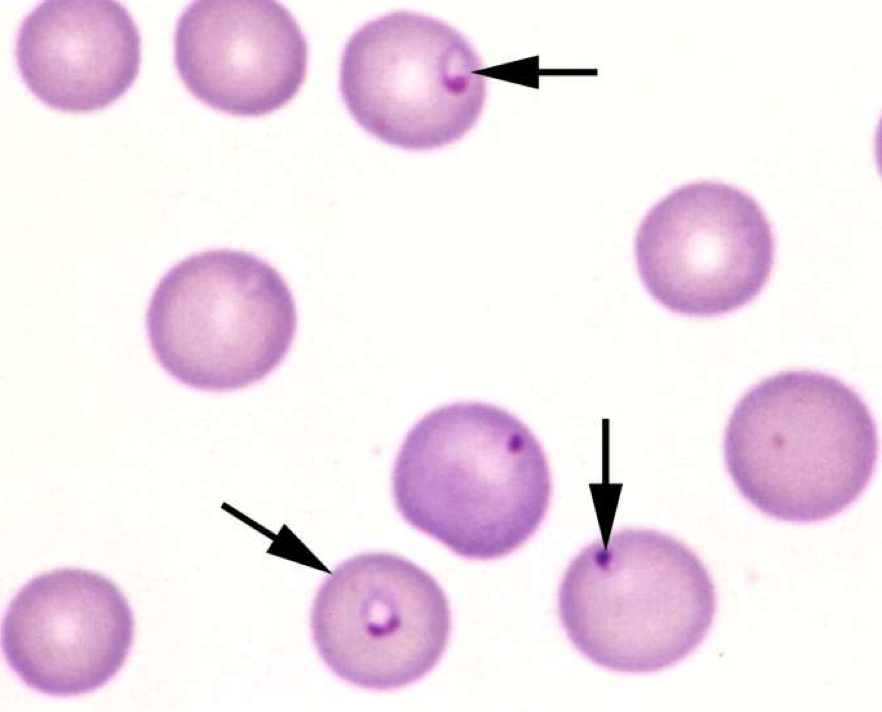
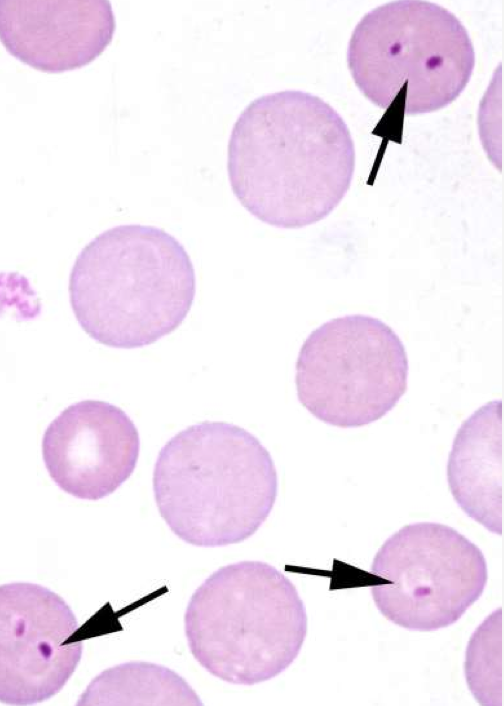
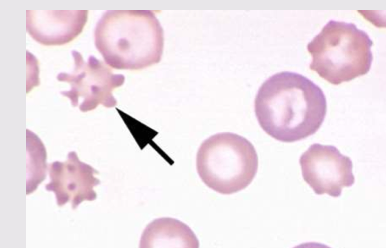
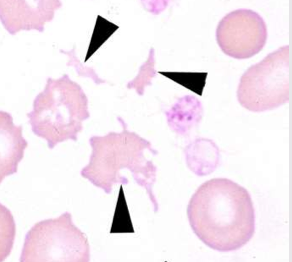

what is this ??

Ecchinocytes
can be caused by
What is this

Schistocytes
Fragmented RBCs
-formed from: Intravascular trauma ( DIC, Vascular tumors) and Iron Deficieny
What is this ??
Keratocyte
” Purse Cells”
What is this ?

Spherocyte
” Beach Ball”
What is this ?
Eccentrocytes
Hg unilateral- clear zone on 1 side
-seen with: Oxidative damage, Onion Injestions
** can be seen with Heinz Bodies
What is this? What stain is used?
Heinz bodies
What is this ?
What stain is used ?
Heinz Body
What is this? When is it normal ?

Basophilic Stippling
What is this ?
Howell Jolly Bodies
What is the agent ??

Mycoplasma haemofelis
In a dog: what is this agent ?
Mycoplasma Haemocanis
What is the agent ??
Cytauxzoon felis
in a dog- what is this agent ?

Babesia canis
In a dog- what is this ??
Babesia gibsoni
In a cow- what is this agent

Mycoplasma wenyoni
What is this agent ??

Anaplasma marginale
What is this cell ?

Mesothelial cell
What cell is this ?
Acanthocyte
What is this cell called ?
Schistocytes
Sensitivity of PCR for Lymphoma is 91%, what does
this mean ??
tests rules OUT a disease (“ SNOUT”)
= 91% of (+) animals will come up (+)
BUT the other 9% thats listed as neg might be false neg
* looking at how much of the % could be a false (-)
A highly specific disease
when its highly specific, a (+) means its most likely (+)
-Helps rule in a disease ( SPIN IT IN)
Tell me about this tube

” Red” - NO anticoagulant
Tell me anout this tube

” Red/Black”= “ Tiger-top”” Marble Top”- Serum Separator
-gel promotes blood clot formation & separtes cells from serum
USED FOR:
Tell me about this

bind up cause uses up Ca+